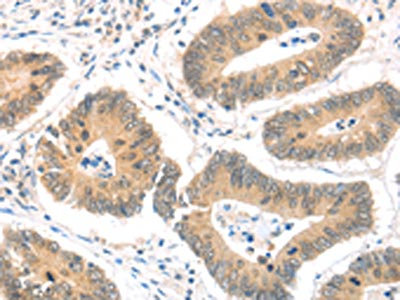

-
中文名稱:MAGED1兔多克隆抗體
-
貨號:CSB-PA145666
-
規格:¥1100
-
圖片:
-
The image on the left is immunohistochemistry of paraffin-embedded Human colon cancer tissue using CSB-PA145666(MAGED1 Antibody) at dilution 1/30, on the right is treated with fusion protein. (Original magnification: ×200)
-
The image on the left is immunohistochemistry of paraffin-embedded Human thyroid cancer tissue using CSB-PA145666(MAGED1 Antibody) at dilution 1/30, on the right is treated with fusion protein. (Original magnification: ×200)
-
Gel: 10%SDS-PAGE, Lysate: 40 μg, Lane 1-3: A549 cells, Jurkat cells, 293T cells, Primary antibody: CSB-PA145666(MAGED1 Antibody) at dilution 1/1200, Secondary antibody: Goat anti rabbit IgG at 1/8000 dilution, Exposure time: 3 minutes
-
-
其他:
產品詳情
-
Uniprot No.:
-
基因名:
-
別名:DLXIN 1 antibody; MAGD1_HUMAN antibody; MAGE D1 antigen antibody; MAGE tumor antigen CCF antibody; MAGE-D1 antigen antibody; Maged1 antibody; Melanoma antigen family D 1 antibody; Melanoma associated antigen D1 antibody; Melanoma-associated antigen D1 antibody; Neurotrophin receptor interacting MAGE homolog antibody; Neurotrophin receptor-interacting MAGE homolog antibody; NRAGE antibody; PP2250 antibody
-
宿主:Rabbit
-
反應種屬:Human,Mouse,Rat
-
免疫原:Fusion protein of Human MAGED1
-
免疫原種屬:Homo sapiens (Human)
-
標記方式:Non-conjugated
-
抗體亞型:IgG
-
純化方式:Antigen affinity purification
-
濃度:It differs from different batches. Please contact us to confirm it.
-
保存緩沖液:-20°C, pH7.4 PBS, 0.05% NaN3, 40% Glycerol
-
產品提供形式:Liquid
-
應用范圍:ELISA,WB,IHC
-
推薦稀釋比:
Application Recommended Dilution ELISA 1:2000-1:5000 WB 1:500-1:2000 IHC 1:25-1:100 -
Protocols:
-
儲存條件:Upon receipt, store at -20°C or -80°C. Avoid repeated freeze.
-
貨期:Basically, we can dispatch the products out in 1-3 working days after receiving your orders. Delivery time maybe differs from different purchasing way or location, please kindly consult your local distributors for specific delivery time.
-
用途:For Research Use Only. Not for use in diagnostic or therapeutic procedures.
相關產品
靶點詳情
-
功能:Involved in the apoptotic response after nerve growth factor (NGF) binding in neuronal cells. Inhibits cell cycle progression, and facilitates NGFR-mediated apoptosis. May act as a regulator of the function of DLX family members. May enhance ubiquitin ligase activity of RING-type zinc finger-containing E3 ubiquitin-protein ligases. Proposed to act through recruitment and/or stabilization of the Ubl-conjugating enzyme (E2) at the E3:substrate complex. Plays a role in the circadian rhythm regulation. May act as RORA co-regulator, modulating the expression of core clock genes such as ARNTL/BMAL1 and NFIL3, induced, or NR1D1, repressed.
-
基因功能參考文獻:
- Our results indicate that NRAGE subcellular localization is related to radiation resistance of esophageal carcinoma cell and EMT may be involved in NRAGE subcellular location. PMID: 29516958
- NRAGE upregulation was correlated with advanced TNM stage, local invasion, and poor survival. Importantly, NRAGE could serve as an independent prognostic factor in patients with gastric cancer. PMID: 29778424
- The nuclear localized NRAGE interacts with RNF8 and BARD1 to mediate the resistance of esophageal carcinomas cells against DNA-damaging agents. PMID: 27035619
- MAGED1 binds and positively regulates the transcriptional activity of family members SIM1, SIM2, NPAS4 and ARNT2, but does not interact with AhR, HIF1alpha and ARNT. This interaction is mediated by PAS repeat regions which also form the interface for bHLH PAS dimerisation, and accordingly MAGED1 is not found in complex with bHLH PAS dimers. PMID: 27472814
- our surprise, NRAGE induces nuclear localization of beta-catenin and increases its DNA binding ability. Further studies reveal that NRAGE leads to the modification of beta-catenin/Arm with O-linked beta-N-acetylglucosamine (O-GlcNAc), and failure of the association between beta-catenin/Arm and pygopus(pygo) protein, which is required for transcriptional activation of Wnt target genes. Therefore, our findings suggest a ... PMID: 28427939
- Loss of GSPT2 and/or MAGED1 function may contribute to the intellectual disability. PMID: 28414775
- The ectopic subcellular localization of NRAGE mediated nuclear translocation of beta-catenin. PMID: 26738870
- High NRAGE expression is associated with esophageal carcinomas. PMID: 24710624
- MAGE-D1 plays important roles in the central nervous system in both developmental and adult stages. PMID: 23314527
- Univariate and multivariate analyses indicated that MAGED1 expression was an independent prognostic factor in colorectal carcinoma PMID: 22935435
- NRAGE may participate in the formation of radioresistance of TE13R120 cells by changing its subcellular localization, but its relationship with cell apoptosis has not been confirmed. PMID: 20868560
- we establish the roles for Dlxin-1, one as an anti-tumorigenic and anti-invasive protein in high-grade gliomas and the other as an inducer of differentiation of glioma stem cells. PMID: 21109781
- Data report that NRAGE, via the same XIAP-Tak1-Tab1 complex, is required for the phosphorylation of IKK -alpha/beta and subsequent transcriptional activation of the p65 subunit of NF-kappaB. PMID: 20100315
- A RING finger protein Praja1 regulates Dlx5-dependent transcription through its ubiquitin ligase activity for the Dlx/Msx-interacting MAGE/Necdin family protein, Dlxin-1. PMID: 11959851
- hNRAGE arrests cell growth through a p53 dependent pathway. hNRAGE also increases the p53 protein level as well as its phosphorylation (Ser392). PMID: 15094062
- The expression pattern of Maged1 roughly summarizes that of Maged2 and Maged3 PMID: 15162511
- MAGE-D1 protein expression was reduced in 6 of 16 breast carcinoma cell lines as compared with untransformed immortal mammary epithelial cell lines; suppression of MAGE-D1 expression may be involved in the tumorigenesis of some sporadic breast cancers. PMID: 15930293
- demonstrate the importance of human NRAGE in homotypic cell-to-cell adhesion and illuminate the mechanism of human NRAGE in the process of inhibition of cell adhesion PMID: 16125672
- Data show that hNRAGE gene can inhibit the growth of 293 cells. PMID: 16388736
- studies indicate for the first time that NRAGE could suppress metastasis of melanoma and pancreatic cancer probably through downregulation of MMP-2 PMID: 17140727
- MAGE-D1 might be a novel inhibitor of angiogenesis in vitro and in vivo. PMID: 17149546
- These findings provide new insight into the ability of MAGE-D1 to suppress the motility and adhesion response of tumor cells by interfering with actin cytoskeleton reorganization and hypoxia inducible factor 1-dependent gene expression. PMID: 17453828
- Che-1 interacts with NRAGE and NRAGE overexpression downregulates endogenous Che-1 by targeting it for proteasome-dependent degradation. PMID: 17488777
- Enhanced expression of MAGE-D1 by gene transfer could reverse the malignant phenotypes of breast cancer cells. PMID: 19639218
顯示更多
收起更多
-
亞細胞定位:Cytoplasm. Cell membrane; Peripheral membrane protein. Nucleus.
-
組織特異性:Expressed in bone marrow stromal cells from both multiple myeloma patients and healthy donors. Seems to be ubiquitously expressed.
-
數據庫鏈接:
Most popular with customers
-
-
YWHAB Recombinant Monoclonal Antibody
Applications: ELISA, WB, IHC, IF, FC
Species Reactivity: Human, Mouse, Rat
-
Phospho-YAP1 (S127) Recombinant Monoclonal Antibody
Applications: ELISA, WB, IHC
Species Reactivity: Human
-
-
-
-
-